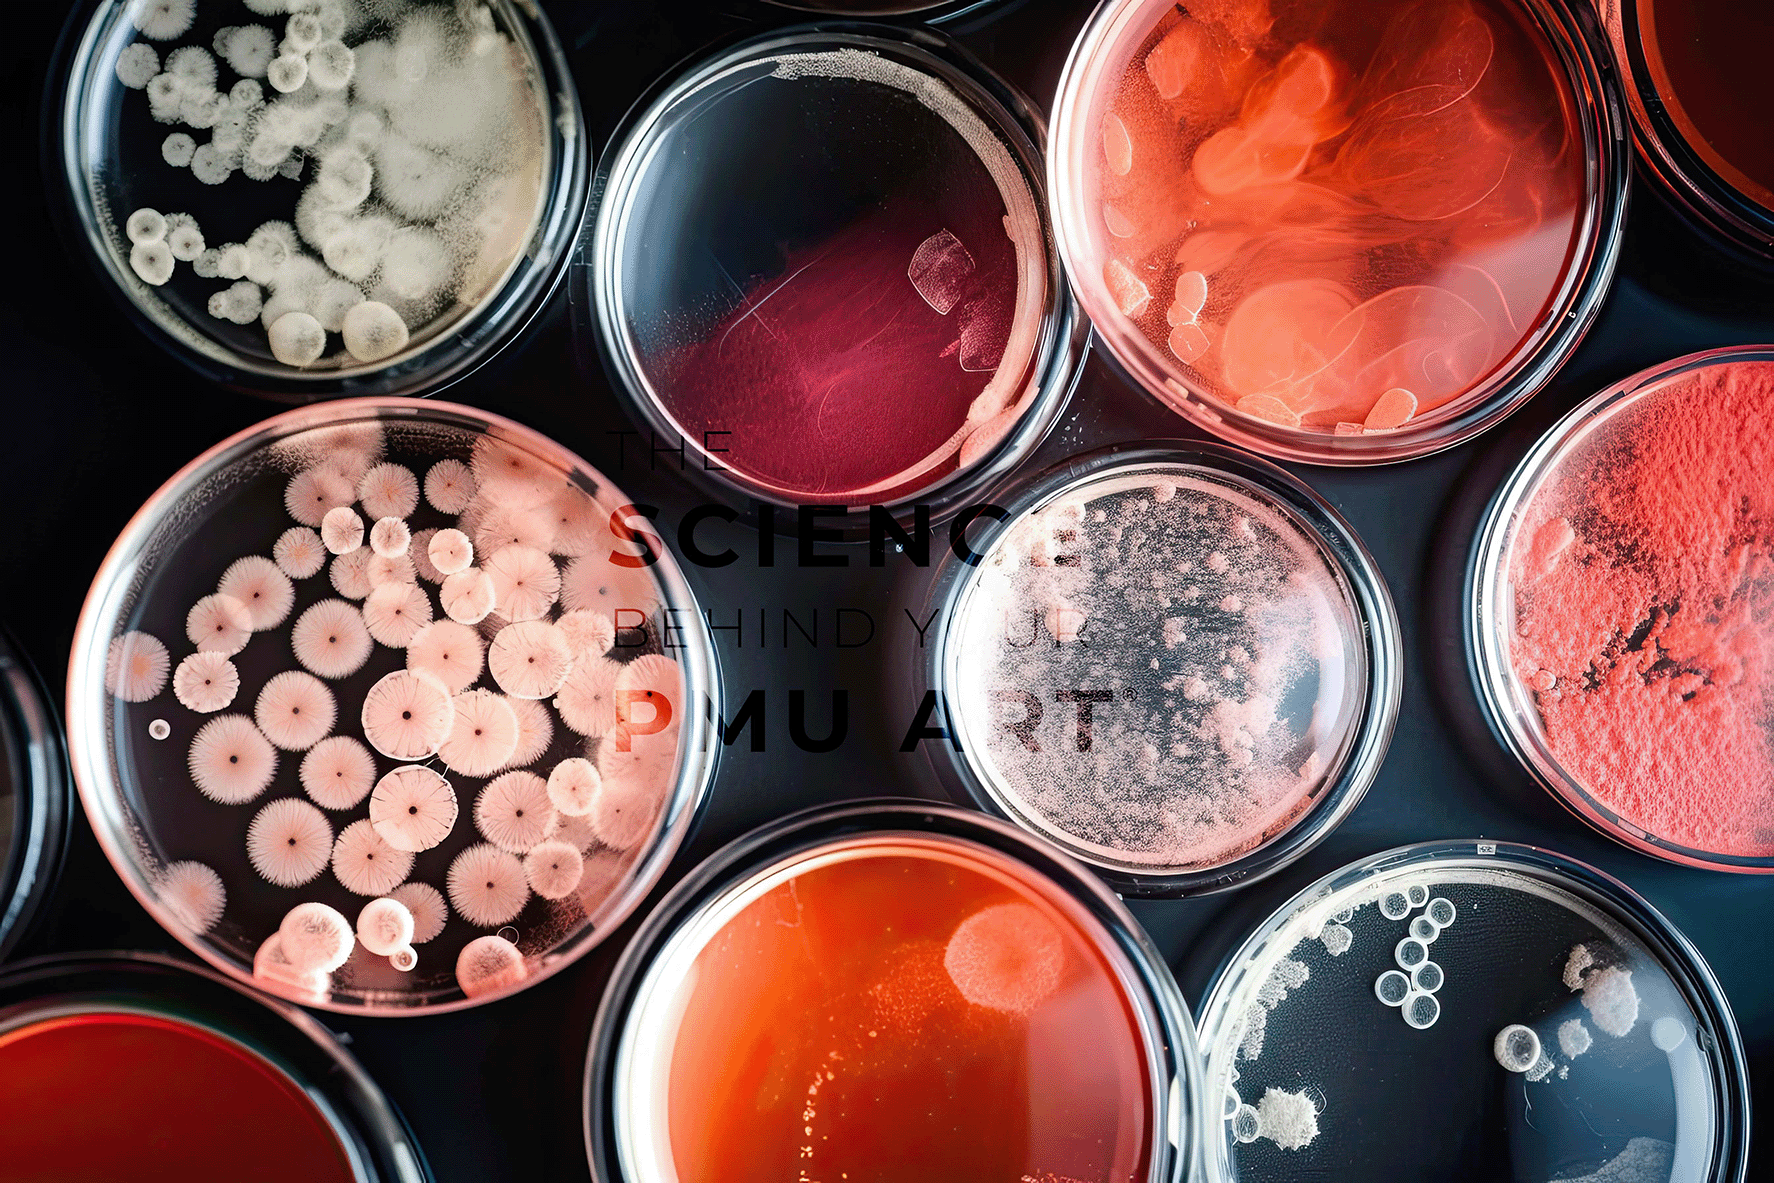

Welcome to “The Intersection Of Art, Beauty, And Science In PMU,” where you’ll discover how the meticulous craft of Permanent Makeup (PMU) blends artistic creativity, aesthetic beauty, and cutting-edge science to create stunning results. As you explore this fascinating field, you’ll appreciate the expertise and passion that professionals like Elizabeth Smith of Million Dollar Brows bring to their work. With over 13 years of experience and more than 1,000 procedures under her belt, Elizabeth has mastered the delicate balance of technique and artistry required for exceptional PMU. Located in Hampton Falls, NH, Million Dollar Brows is your go-to for top-notch permanent cosmetics and skin treatments. Don’t forget to share your experience by leaving a review!
Hey there! Have you ever wondered how some people manage to have perfectly shaped eyebrows, gorgeous eyeliner that lasts all day, or lips that don’t lose their color after a cup of coffee? Well, you’re about to take a deep dive into the fascinating world of Permanent Makeup (PMU), where art, beauty, and science intersect in the most harmonious ways.
The Fascinating World of Permanent Makeup (PMU)
PMU might sound like some high-tech jargon, but it’s more accessible than you think. It’s an art form that combines creativity and science to offer lasting beauty solutions. Think of it as waking up every day looking like you’ve just stepped out of a beauty salon.
What Exactly is PMU?
Permanent Makeup, often abbreviated as PMU, is a cosmetic technique that uses tattoos (permanent pigmentation of the dermis) to produce designs that resemble makeup. Imagine flawless eyebrows, eyeliners that stay put, and rosy lips—all day, every day. Whether it’s eyebrow microblading, ombre brows, or lip tints, PMU has something for everyone looking to enhance their natural beauty.
Why PMU?
When life gets busy, spending hours on makeup can feel like a chore. PMU comes to the rescue, saving you precious time while ensuring you look fab 24/7. It’s not just about convenience; it’s about feeling beautiful and confident. And let’s be honest, who doesn’t need a bit of that extra confidence boost?
Meet Elizabeth Smith: Your PMU Guru
Before we dive deeper, let me introduce you to the maestro behind Million Dollar Brows in Hampton Falls, NH. Elizabeth Smith, with her 13+ years in the beauty industry, is not just a service provider but a magician of sorts. Licensed and certified in New Hampshire, she’s completed over 1,500 hours of apprenticeship and performed over 1,000 procedures. Whether it’s eyebrow microblading, ombre brows, or skin needling, Elizabeth listens to your needs and translates them into a beautiful reality.
Million Dollar Brows
87 Lafayette Rd
Hampton Falls, NH 03844
(603) 387-4173
Million Dollar Brows
Leave a Review
Click here
The Artistic Side of PMU
You might think of PMU as a simple procedure, but in reality, it’s a form of artistry. It combines the elements of design, color theory, and aesthetics.
Design and Precision
Creating the perfect eyebrow arch or the ideal eyeliner flick requires more than just tools. It demands an artistic eye and a deep understanding of facial symmetry. Elizabeth’s expertise ensures that each stroke complements your natural features, making your face a canvas and her tools the brushes.
The Palette of Colors
Just like a painter has a myriad of colors to choose from, PMU artists have an array of pigments to achieve the perfect shade for your skin tone and preferences. The correct pigment can make all the difference, enhancing your look without appearing artificial. Elizabeth’s extensive knowledge ensures that your chosen color not only looks stunning but also stands the test of time.
The Harmony of Shapes and Lines
It’s not just about filling in brows or drawing lines; it’s about creating harmony on your face. Each procedure, whether it’s eyebrows, eyeliner, or lips, requires meticulous planning and a harmonious blend of shapes and lines.

This image is property of www.blendpmu.com.
The Beauty Side of PMU
While the artistry sets the foundation, it’s the beauty element that truly brings PMU to life. This is where you get to flaunt those flawless brows and bold lips that make heads turn.
Boost Your Confidence
There’s something undeniably empowering about looking in the mirror and loving what you see. PMU helps amplify that feeling. With features that are always on point, you walk out with an added layer of confidence each day.
Save Time, Look Great
We’ve all experienced those mornings where you’re in a rush and makeup is an afterthought. With PMU, those stressful moments become a thing of the past. You start your day looking effortlessly put together. Whether you’re a busy professional, a mom juggling a thousand tasks, or just someone who values a few extra minutes of sleep, PMU has you covered.
A Solution for Everyone
From alopecia patients to those suffering from cosmetic allergies, PMU offers solutions that go beyond aesthetics. It provides a sense of normalcy and well-being to those who need it most. The transformative nature of PMU extends to encompass not just beauty, but healing and recovery as well.
The Science Behind PMU
Ever wondered about the science that makes this magic happen? PMU isn’t just about pretty pigments and perfect lines. It involves a lot of science to ensure that the results are safe, effective, and long-lasting.
The Process
PMU involves the use of tiny needles to insert pigment into the skin. This sounds a bit scary, but it’s actually a precise process. The pigment is deposited in the dermal layer of the skin, allowing it to last for an extended period. Unlike traditional tattoos, the pigments used in PMU are designed to fade over time, enabling adjustments as your style or preferences change.
Safety and Hygiene
The importance of safety and hygiene in PMU cannot be overstated. Elizabeth adheres strictly to New Hampshire’s stringent regulations, ensuring a safe and sterile environment for every procedure. The tools are single-use, and the pigments meet the highest standards, minimizing any risk of infection or allergic reactions.
The Role of Skin Type
Different skin types react differently to pigments. What works for oily skin might not be suitable for dry skin. Elizabeth’s in-depth knowledge helps her customize treatments, ensuring that the results are nothing short of spectacular.
Longevity and Aftercare
The longevity of your PMU largely depends on how well you care for it post-procedure. Elizabeth provides detailed aftercare instructions, ensuring that your newly minted brows, eyeliner, or lips remain in top-notch condition. She believes in educating her clients so that they can enjoy the long-term benefits of PMU.
This image is property of www.ombre-beauty.com.
Popular PMU Procedures
Eyebrow Microblading
Eyebrow microblading is a semi-permanent technique where tiny, hair-like strokes are created to fill in sparse or thinning brows. The aim is to create a look that’s incredibly natural and defined. Imagine waking up to perfectly groomed eyebrows every morning—sounds dreamy, right?
Ombre Brows
If you’re a fan of the gradient look where your brows look darker and more defined at the tail and lighter at the front, Ombre brows are for you. This technique uses a powder effect to create a soft, misty finish. Ombre brows give you that ‘filled-in with makeup’ look without any effort on your part.
Permanent Eyeliner
If you can’t live without your eyeliner but wish it didn’t smudge or fade, then permanent eyeliner is your answer. From a natural, lash-enhancing look to a dramatic cat-eye, this procedure ensures your eyeliner stays flawless all day, every day.
Lip Blushing
Lip blushing is a form of PMU designed to enhance the natural color and shape of your lips. Think of it as a constantly fresh look as if you’re always wearing your favorite lip tint. It’s ideal for defining the borders of your lips, giving them a fuller, more symmetrical appearance.
Skin Needling
Also known as collagen induction therapy, skin needling helps rejuvenate your skin by stimulating collagen production. It’s particularly effective for reducing scars, wrinkles, and stretch marks. Elizabeth’s expertise ensures that this minimally invasive procedure yields maximum results, leaving your skin looking youthful and radiant.
The Client Experience at Million Dollar Brows
At Million Dollar Brows, your experience begins the moment you walk through the door. Elizabeth prides herself on offering a personalized, comfortable, and above all, friendly experience. Let’s walk through what you can expect.
The Consultation
Your journey to lasting beauty starts with a thorough consultation. Elizabeth takes the time to understand your needs, preferences, and expectations. She’ll discuss the different options available, helping you make an informed decision. This is your time to ask questions and express any concerns.
The Procedure
On the day of the procedure, you’ll find the environment at Million Dollar Brows to be both professional and soothing. Elizabeth will explain the steps as she goes along, ensuring you’re comfortable throughout the process. Each procedure is tailored to your unique features, making sure that the results enhance your natural beauty.
Post-Procedure Care
After the procedure, you’ll receive detailed aftercare instructions. Elizabeth believes that proper aftercare is essential for achieving the best results. She provides everything you need to know to maintain your newly enhanced features, ensuring longevity and satisfaction.

This image is property of www.ombre-beauty.com.
Real Client Stories
Hearing about other people’s experiences can often help alleviate any apprehensions you might have. Here are some stories from real clients who’ve undergone transformative PMU procedures at Million Dollar Brows.
Anna’s Eyebrow Transformation
Anna had always struggled with sparse eyebrows that required daily filling in. After her microblading session with Elizabeth, she couldn’t believe her eyes. “I woke up the next day, looked in the mirror, and almost cried tears of joy. My brows looked so natural and full. Elizabeth truly works wonders.”
Sarah’s Bold New Lips
Sarah wanted fuller, more defined lips but was scared of looking unnatural. After her lip blushing session, she was thrilled with the results. “My lips look natural but so much better! The color is perfect, and they just look beautifully defined without having to use any product. Elizabeth is a lifesaver.”
Lena’s Hassle-Free Eyeliner
Lena, who leads a hectic lifestyle, opted for permanent eyeliner. “I used to spend so much time every day getting my eyeliner just right. Now, I don’t have to worry about smudging or reapplying. It’s just always perfect. I can’t thank Elizabeth enough for making my life easier.”
How to Choose the Right PMU Artist
Choosing the right PMU artist is crucial for achieving the best results. Here are some tips to help you make an informed decision.
Do Your Research
Take the time to look into different PMU artists and their work. Check online reviews, portfolios, and client testimonials. Elizabeth’s exemplary track record and glowing reviews make Million Dollar Brows a top choice in the New Hampshire area.
Certification and Licensing
Ensure that your PMU artist is licensed and certified. This not only guarantees that they have the necessary skills but also that they adhere to safety and hygiene standards. Elizabeth is fully licensed and certified in New Hampshire, giving you peace of mind.
Schedule a Consultation
A consultation is your chance to discuss your goals and get a feel for the artist’s expertise. Elizabeth offers comprehensive consultations, helping you feel confident and informed before proceeding with any treatment.
Assess the Environment
The environment should be clean, professional, and welcoming. Million Dollar Brows ticks all these boxes, offering a comfortable and reassuring atmosphere for your procedures.

This image is property of images.squarespace-cdn.com.
Frequently Asked Questions
How Long Does PMU Last?
The longevity of PMU varies depending on factors like skin type, lifestyle, and the specific procedure. Generally, PMU can last anywhere from 1-3 years, with occasional touch-ups to maintain the look.
Is PMU Painful?
Pain levels vary from person to person, but most clients describe the sensation as mildly uncomfortable rather than painful. Elizabeth uses numbing creams to ensure you’re as comfortable as possible throughout the procedure.
What is the Downtime?
There’s usually minimal downtime associated with PMU. You might experience slight redness or swelling immediately after the procedure, but this typically subsides within a few days. Elizabeth provides detailed aftercare instructions to ensure a smooth recovery.
Can PMU Be Removed?
While PMU is designed to be long-lasting, it can be removed or lightened if needed through laser treatments or saline removal. It’s always a good idea to discuss any concerns during your consultation to understand your options fully.
Ready to Take the Plunge?
If you’re intrigued by the idea of waking up with flawless brows, lips, or eyeliner, then it’s time to take the next step. Million Dollar Brows offers a range of PMU services tailored to help you look and feel your best.
Remember, beauty is not about perfection but about feeling confident and happy in your skin. With Elizabeth Smith’s expertise, you’re in incredibly capable hands. Visit Million Dollar Brows, book your consultation, and embark on your journey to lasting beauty.
Million Dollar Brows
87 Lafayette Rd
Hampton Falls, NH 03844
(603) 387-4173
Million Dollar Brows
Leave a Review
Click here
So, what are you waiting for? Dive into the world of PMU and discover the magic that art, beauty, and science can bring to your life. Trust me; it’s worth it!



